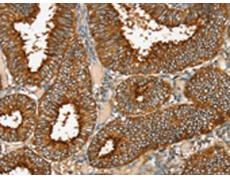
一抗

中文名稱:兔抗RAB25多克隆抗體
英文名稱: Anti-RAB25 rabbit polyclonal antibody
別 名: CATX-8; RAB11C
相關(guān)類別: 一抗
儲(chǔ) 存: 冷凍(-20℃)
宿 主: Rabbit
抗 原: RAB25
反應(yīng)種屬: Human, Mouse
標(biāo)記物: Unconjugate
克隆類型: rabbit polyclonal
技術(shù)規(guī)格
|
Background: |
RAB proteins, such as RAB25, are members of the RAS superfamily of small GTPases that are involved in membrane trafficking. Members of the RAB11 subfamily, including RAB25, control the return of internalized membrane-associated moieties to the cell surface. |
|
Applications: |
ELISA, IHC |
|
Name of antibody: |
RAB25 |
|
Immunogen: |
Fusion protein of human RAB25 |
|
Full name: |
RAB25, member RAS oncogene family |
|
Synonyms: |
CATX-8; RAB11C |
|
SwissProt: |
P57735 |
|
ELISA Recommended dilution: |
2000-5000 |
|
IHC positive control: |
Human cervical cancer and human thyroid cancer |
|
IHC Recommend dilution: |
40-150 |

 購物車
購物車 幫助
幫助
 021-54845833/15800441009
021-54845833/15800441009